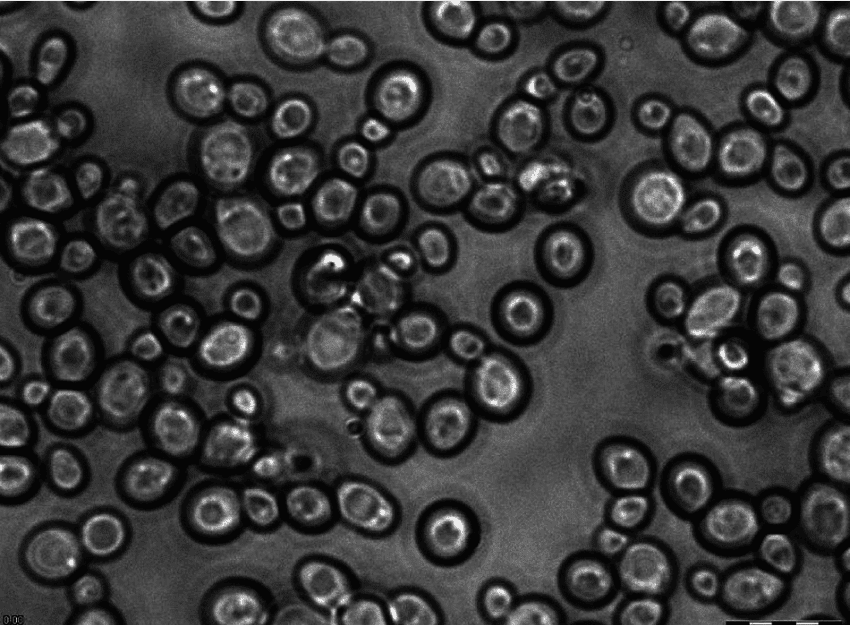
Levadura de panadero bajo el microscopio

¿Eres de los que se siente confundido al diferenciar bacterias de levaduras? En ese caso, solo tendrá que leer este artículo ahora mismo.
¿Cuáles son las diferencias entre bacterias y levaduras?
Aunque tanto las bacterias como las levaduras son microorganismos unicelulares, existe una serie de elementos que los distinguen. De la familia a la organización, de la forma al tamaño, casi todo es diferente en ambos. Si bien tenemos bacterias de la familia Monera, la levadura es un hongo.
Cuando se ve bajo un microscopio, la levadura se parece más a un óvalo; por otro lado, las bacterias se asemejan a una varilla hasta cierto punto. Aparte de todos estos, hay otros actores distintivos; siga leyendo para obtener más información.
¿Qué son las bacterias?
Las bacterias son microbios unicelulares. Estos son los organismos que no son visibles a simple vista. Las bacterias pueden ser útiles y dañinas al mismo tiempo. Estos organismos estuvieron entre las primeras formas de vida que aparecieron en la madre tierra y todavía están presentes a nuestro alrededor en diversas formas.
Las bacterias tienen nuestras formas comunes, a saber,
 Coco bacteria bajo microscopio
Coco bacteria bajo microscopio
- forma de coco
- forma de bacilo
- forma de espirilla
- forma de vibrión
¿Qué es una levadura?
En pocas palabras, la levadura es un hongo unicelular. Estos también son microorganismos y es imposible verlos a simple vista. Al igual que la mayoría de los otros hongos, la levadura necesita alimento, humedad y calor para crecer. Aunque se utilizan en el proceso de producción de cerveza, pan y varios tipos de antibióticos, estos microorganismos también pueden afectar negativamente su salud. Bastante similar a las bacterias, la levadura también tiene cuatro tipos generales.
- Levadura de panadería
- Levadura nutricional
- Levadura
- Levadura de destilería y de vino
Levadura de panadero bajo el microscopio
Levadura de panadero bajo el microscopio
Diferencia entre bacterias y levaduras
Organización
Las bacterias se clasifican como procariotas, mientras que las levaduras se clasifican como eucariotas.
Reino
Las bacterias pertenecen a la familia Monera. Por otro lado, la levadura figura entre los miembros de la familia de los hongos.
Forma y tamaño
Cuando se observan bajo un microscopio, las bacterias parecen ser esféricas o en forma de varilla. Por lo general, son células pequeñas que se organizan en grupos. La levadura, por otro lado, es comparativamente más grande y se asemeja a la forma de un óvalo.
Pared celular
La composición de las paredes celulares tanto en bacterias como en levaduras es bastante diferente, donde la de las bacterias está compuesta de mureína, la misma de las levaduras está compuesta de quitina.
Disponibilidad de Núcleo
En el caso de la levadura, cada célula comprende un núcleo. Por otro lado, el núcleo está completamente ausente en las bacterias.
Disponibilidad de orgánulos unidos a membrana
Las bacterias carecen de cualquier tipo de orgánulos unidos a la membrana, mientras que no se puede decir lo mismo de la levadura. De hecho, estos están compuestos de mitocondrias, lisosomas, aparato de Golgi y otros tipos de orgánulos basados en membranas.
ADN
El ADN de la levadura tiene que ver con los cromosomas lineales. Por el contrario, el ADN de las bacterias presenta cromosomas celulares únicos.
Proceso de respiración
Las bacterias respiran a través de un método de respiración aeróbica o anaeróbica. El mismo proceso en levadura implica la fermentación de etanol.
Ribosomas
Las bacterias tienen los ribosomas 70S, mientras que las levaduras tienen los 80S.
Disponibilidad de Pili
Si bien las bacterias pueden contener pili, está completamente ausente en la levadura. Si te preguntas qué es pili en realidad, déjanos una idea rápida. Pili es un término para los filamentos más cortos de la proteína llamada pilina. Estos generalmente emergen de la propia membrana citoplasmática.
Movilidad
Las bacterias son móviles. Tienden a realizar sus movimientos con la ayuda de flagelos. Sin embargo, las levaduras son totalmente inmóviles.
Proceso de Reproducción
Las levaduras continúan con el proceso de reproducción mediante un proceso conocido como gemación. Las bacterias, por el contrario, se multiplican por fisión binaria.
Valor de pH óptimo
El valor de pH vuelve a ser un factor diferenciador entre bacterias y levaduras. Al mismo tiempo, el primero tiene un valor de pH que se encuentra entre 6,5 y 7, lo mismo para el segundo se mantiene entre 4 y 4,6.
Uso
El papel de las bacterias es inmenso en la producción de varios tipos de antibióticos. Además, estos microorganismos son útiles para sintetizar varios productos químicos. La levadura, por otro lado, ayuda en la fabricación de cerveza, pan y otras cosas notables.
Enfermedades Causadas
El contacto directo o indirecto con bacterias dañinas puede provocar diversas enfermedades como neumonía, tuberculosis, cólera, tétanos y más. Cuando hablamos de las enfermedades causadas por levaduras, en cambio, tenemos micosis, infecciones vaginales, candidiasis, entre las más frecuentes.
Cuadro comparativo: bacterias frente a levaduras
ParametersBacteriaYeastOrganizationProkaryotesEukaryotesKingdomMoneraFungiShape and SizeRod shaped (Smaller)Oval (Comparatively bigger)Cell Wall CompositionMureinChitinAvailability of NucleusUnavailableOne per cellAvailability of Membrane Bound OrganellesUnavailableAvailableDNASingle circular chromosomeLinear chromosomeProcess of RespirationAerobic or anaerobicEthanol fermentationRibosome70S80SAvailability of PiliAvailableUnavailableMobilityMobileImmobileReproductionBinary fissionBuddingpH Value6.5-74-4.6UsageProduction of useful chemicalsProduction of bread, beer, y másEnfermedades CausadasTB, Cólera, Neumonía, tétanos, etc.Micosis, Candidiasis, Infección vaginal
Similitudes: ¿En qué se parecen las bacterias a la levadura?
Formulario
Tanto las bacterias como las levaduras son microorganismos unicelulares.
Proceso de digestión
Ya sea que hablemos de bacterias o levaduras, ambas se someten a digestión extracelular.
Producción de antibióticos
Aunque las bacterias y las levaduras tienen propiedades de uso que se extienden en diferentes direcciones, una cosa que es similar en ambas es su importancia en la producción de antibióticos.
Nutrición
Otros factores que hacen que las bacterias y las levaduras residan bajo el mismo techo incluyen el hecho de que ambas son heterótrofas, lo que significa que se nutren de varias sustancias orgánicas complejas.
Preguntas frecuentes
¿Cuál es más grande entre las bacterias y las levaduras?
Aunque el tamaño de las levaduras varía, generalmente son más grandes en comparación con las células bacterianas. Esta es una de las razones por las que son miembros de microorganismos de nivel superior, conocidos popularmente como hongos.
¿Cuáles son más dañinas, las bacterias frente a las levaduras?
Tanto las bacterias como las levaduras pueden dañar su cuerpo de diferentes maneras. Mientras que el primero tiene la razón principal de causar varias enfermedades, como la tuberculosis, el cólera, el tétanos y más, la levadura puede causar infecciones vaginales, micosis e incluso candidiasis.
Conclusión
Tanto las bacterias como las levaduras son microorganismos con diferentes estructuras y características. En este artículo, hemos discutido la mayoría de los factores que ayudan a ubicar a ambos organismos unicelulares en cajas distintas. ¿Tienes más para mirar? Asegúrate de hacérnoslo saber.
